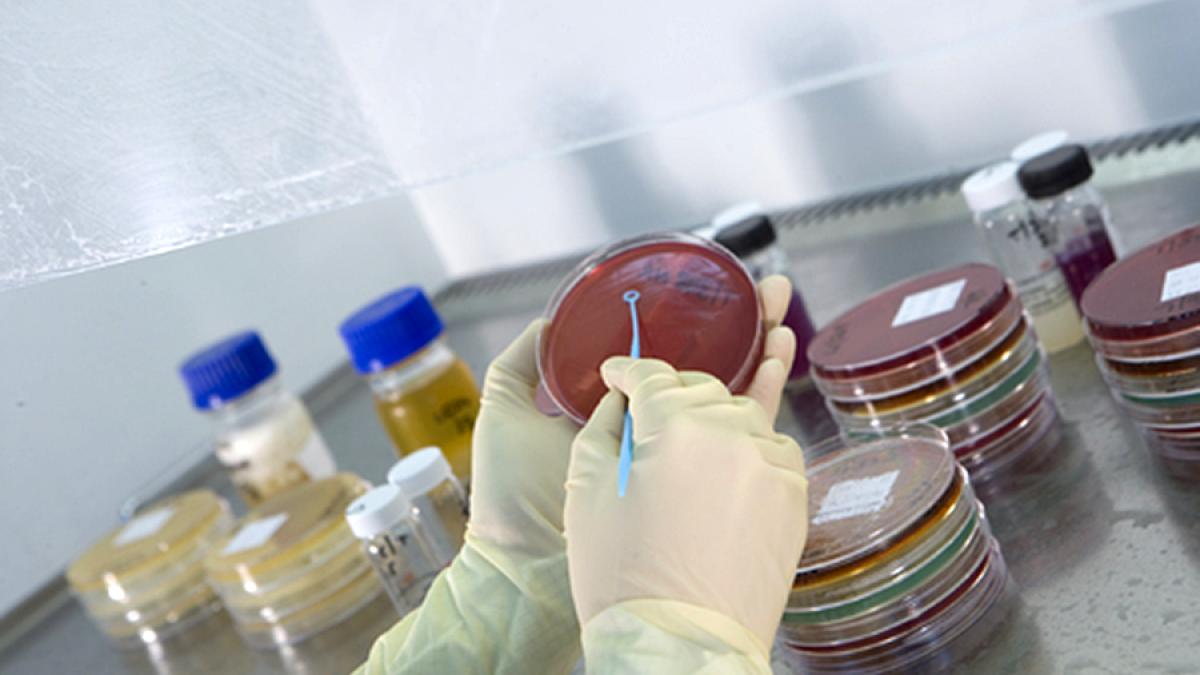
glaxosmithkline_97595700

Adjuvantul poate reduce cantitatea de vaccin necesară per doză, permite imunizarea mai multor persoane și creează o imunitate de lungă durată, se spune într-o declarație oficială a Glaxo, citat de Bloomberg.
Producătorul britanic de medicamente a semnat un acord cu Sanofi ca să ofere tehnologia sa pentru a ajuta la dezvoltarea unui vaccin experimental cu gigantul farmaceutic francez.
Glaxo spune că intenționează să producă adjuvantul în mai multe fabrici din Europa, Canada și SUA.
Vaccin impotriva Covid-19. 10 cei mai promițători candidați
Compania farmaceutică britanică spune că nu se așteaptă să facă profit, banii pe care îi va câștiga vor fi investiți pentru a sprijini cercetarea și pregătirea pandemiei pe termen lung.
Directorul executiv Emma Walmsley a declarat luna trecută că obiectivul pactului cu Sanofi este de a face sute de milioane de doze anual până la sfârșitul anului viitor. Într-o colaborare cu Coaliția pentru Pregătire și Inovare pentru Pandemie, Glaxo a acceptat, de asemenea, să împărtășească know-how-ul său cu alți dezvoltatori de vaccinuri, începând cu Universitatea Queensland din Australia.
"Va fi nevoie de mai mult de un vaccin pentru a face față acestei pandemii globale", a declarat Roger Connor, președintele operațiunii cu vaccinuri ale Glaxo.